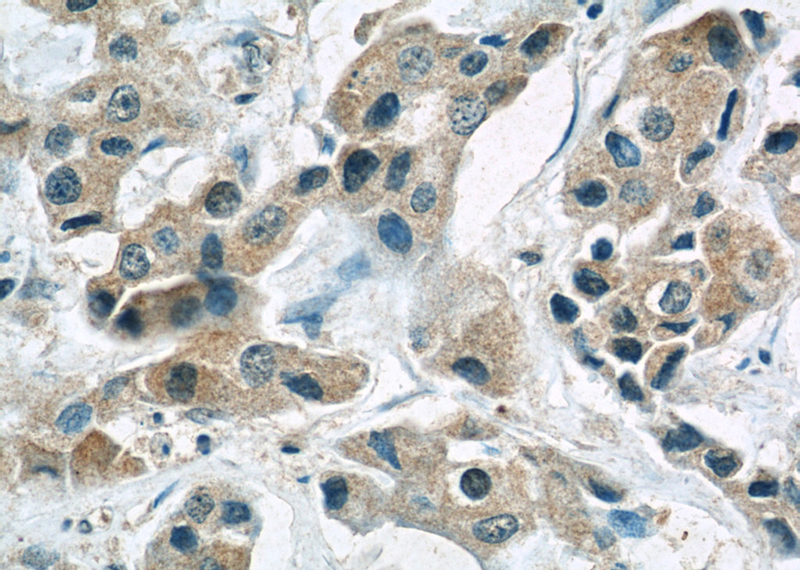

-
Product Name
MCL1 antibody
- Documents
-
Description
MCL1 Mouse Monoclonal antibody. Positive IHC detected in human breast cancer tissue. Positive IF detected in MCF-7 cells, Hela cells. Positive WB detected in Hela cells, A431 cells, Jurkat cells. Observed molecular weight by Western-blot: 40 kDa
-
Tested applications
ELISA, WB, IF, IHC
-
Species reactivity
Human; other species not tested.
-
Alternative names
EAT antibody; Mcl 1 antibody; Mcl 1l antibody; Mcl 1s Delta TM antibody; MCL1 antibody; mcl1/EAT antibody; MCL1L antibody; MCL1S antibody
-
Isotype
Mouse IgG2b
-
Preparation
This antibody was obtained by immunization of MCL1 recombinant protein (Accession Number: NM_021960). Purification method: Protein A purified.
-
Clonality
Monoclonal
-
Formulation
PBS with 0.02% sodium azide and 50% glycerol pH 7.3.
-
Storage instructions
Store at -20℃. DO NOT ALIQUOT
-
Applications
Recommended Dilution:
WB: 1:500-1:5000
IHC: 1:20-1:200
IF: 1:10-1:100
-
Validations

HeLa cells were subjected to SDS PAGE followed by western blot with Catalog No:107418(MCL1 antibody) at dilution of 1:1000

Immunohistochemical of paraffin-embedded human breast cancer using Catalog No:107418(MCL1 antibody) at dilution of 1:50 (under 10x lens)
Immunohistochemical of paraffin-embedded human breast cancer using Catalog No:107418(MCL1 antibody) at dilution of 1:50 (under 40x lens)

Immunofluorescent analysis of MCF-7 cells, using MCL1 antibody Catalog No: at 1:25 dilution and Rhodamine-labeled goat anti-mouse IgG (red).
-
Background
MCL-1 is an anti-apoptotic member of the Bcl-2 family originally isolated from the ML-1 human myeloid leukemia cell line. Similar to BCL2 and BCL2L1, MCL1 can interact with BAX and/or BAK1 to inhibit mitochondria-mediated apoptosis. Mcl-1 is critical for the proliferation and survival of myeloma cells in vitro, and overexpression of Mcl-1 protein in myeloma cells is associated with relapse and short event-free survival in multiple myeloma patients. Recent studies show that MCL-1 is upregulated in numerous haematological and solid tumour malignancies. Therefore, MCL-1 has been suggested as a potential new therapeutic target.
-
References
- Jiang W, Wang Z, Li X. Reduced high-mobility group box 1 expression induced by RNA interference inhibits the bioactivity of hepatocellular carcinoma cell line HCCLM3. Digestive diseases and sciences. 57(1):92-8. 2012.
- Sun Y, Liu Z, Zou X. Mechanisms underlying 3-bromopyruvate-induced cell death in colon cancer. Journal of bioenergetics and biomembranes. 47(4):319-29. 2015.
- Hu H, Tang C, Jiang Q. Reduced ubiquitin-specific protease 9X expression induced by RNA interference inhibits the bioactivity of hepatocellular carcinoma cells. Oncology letters. 10(1):268-272. 2015.
Related Products / Services
Please note: All products are "FOR RESEARCH USE ONLY AND ARE NOT INTENDED FOR DIAGNOSTIC OR THERAPEUTIC USE"
